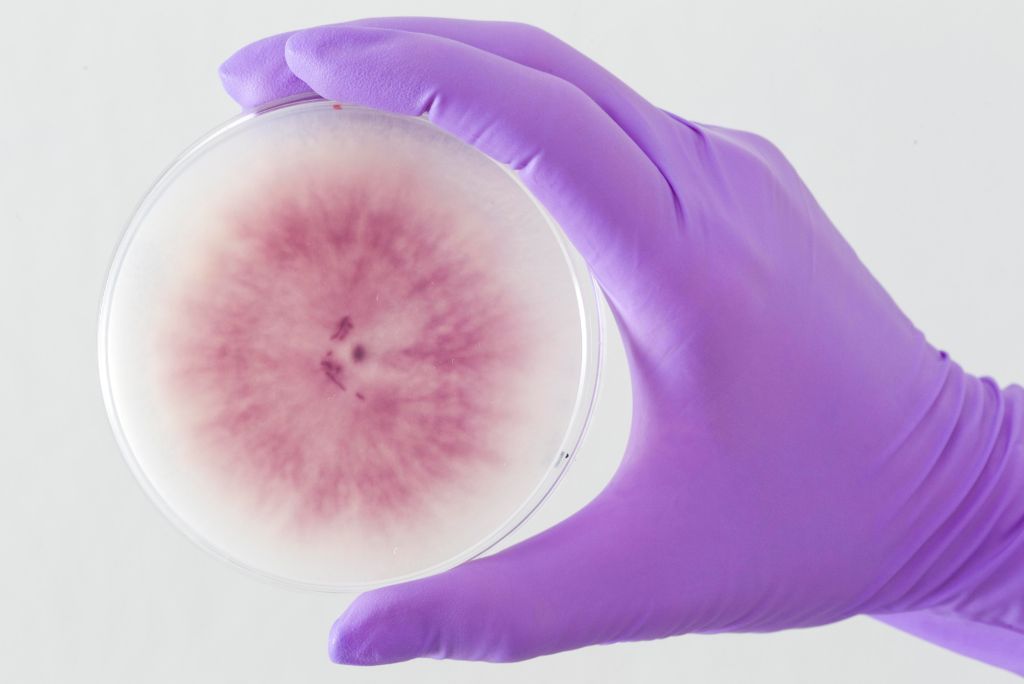

Diagnostični laboratorij Oddelka za varstvo rastlin (OVR-LAB) sestavljajo štirje laboratoriji:
V Diagnostičnem laboratoriju Oddelka za varstvo rastlin izvajamo sledeče naloge:
- laboratorijske analize na prisotnost škodljivih organizmov rastlin z akreditiranimi in neakreditiranimi diagnostičnimi metodami, in sicer za ogorčice (nematode), žuželke, glive in oomicete, rastlinske viruse in viroide ter bakterije
- shranjevanje zbirk ogorčic, žuželk, gliv in oomicet, virusov in viroidov ter bakterij
- raziskave v okviru projektov, ki vključujejo delo s karantenskimi in drugimi škodljivimi organizmi
- druge aktivnosti uradnih in nacionalnih referenčnih laboratorijev
Diagnostični laboratorij Oddelka za varstvo rastlin je s strani UVHVVR imenovan kot karantenska postaja.
V okviru Diagnostičnega laboratorija Oddelka za varstvo rastlin delujejo sledeči Nacionalni referenčni laboratoriji (NRL) in Uradni laboratoriji (UL) za določanje škodljivih organizmov rastlin:
- Nacionalni referenčni laboratorij za ogorčice
- Nacionalni referenčni laboratorij za viruse, viroide in fitoplazme: virusi in viroidi poljščin, sadnega drevja in vinske trte (partner konzorcija)
- Nacionalni referenčni laboratorij za glive in oomicete: na poljščinah, vrtninah in sadnih rastlinah, oomicete na vseh rastlinah (partner konzorcija)
- Nacionalni referenčni laboratorij za insekte in pršice: insekti in pršice na kmetijskih in okrasnih rastlinah (partner konzorcija)
- Uradni laboratorij za ogorčice
- Uradni laboratorij za viruse in viroide na sadnem drevju, vinski trti in poljščinah
- Uradni laboratorij za glive in oomiocete
- Uradni laboratorij za insekte in pršice na kmetijskih in okrasnih rastlinah
Kontaktne osebe
- Vodja Diagnostičnega laboratorija Oddelka za varstvo rastlin (OVR-LAB): dr. Barbara Gerič Stare
- Vodja NRL za ogorčice: dr. Saša Širca
- Vodja NRL za viruse, viroide in fitoplazme: dr. Irena Mavrič Pleško
- Vodja NRL za glive in oomicete: dr. Janja Zajc
- Vodja NRL za insekte in pršice: dr. Špela Modic
- Sprejem vzorcev: Mojca Opara in Dani Dobrovoljc
Akreditacija
Diagnostični laboratorij Oddelka za varstvo rastlin je akreditiran pri Slovenski akreditaciji kot preskuševalni laboratorij po standardu SIST EN ISO/IEC 17025:2017 (priloga).